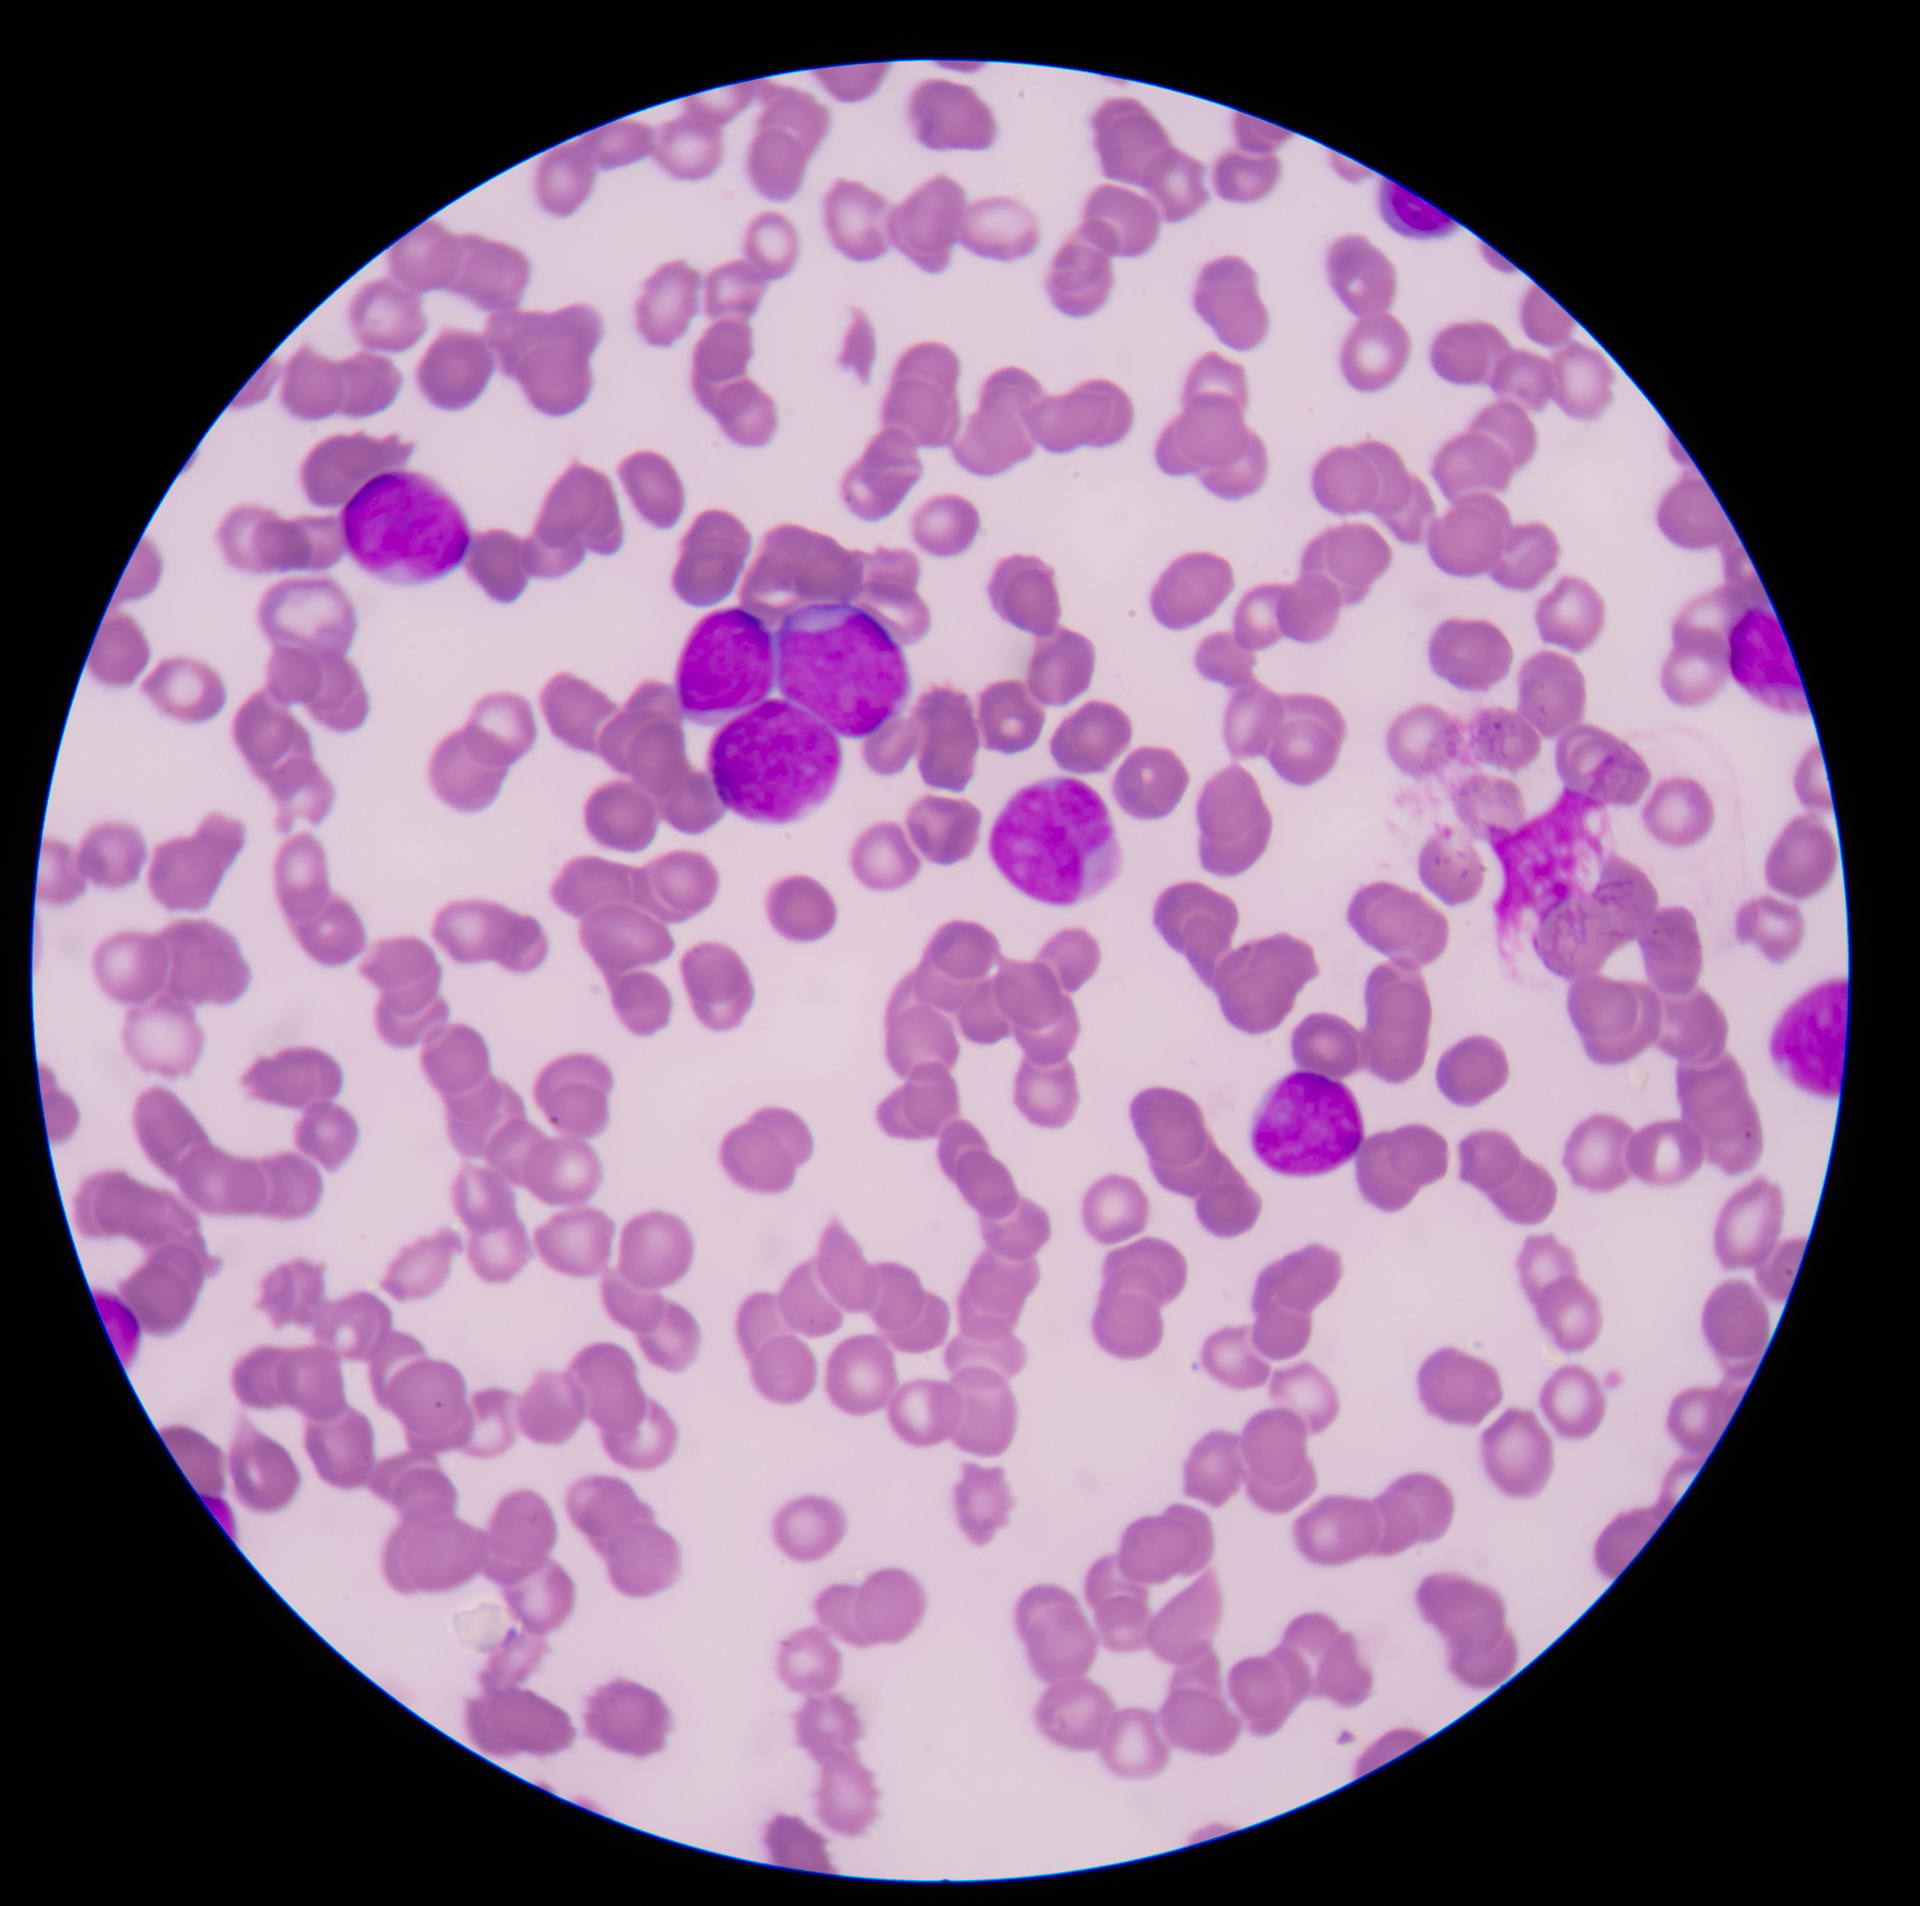
Dreamstime Xxl 65597537 6448080d10698

An international coalition of biomedical researchers co-led by Alexander Bick, MD, PhD, at Vanderbilt University Medical Center has determined a new way to measure the growth rate of precancerous clones of blood stem cells that one day could help doctors lower their patients’ risk of blood cancer.
The technique, called PACER, led to the identification of a gene that, when activated, drives clonal expansion. The findings, published April 12 in the journal Nature, suggest that drugs targeting this gene, may be able to suppress clonal growth and associated cancers.
The PACER technique for determining the “passenger-approximated clonal expansion rate” was applied to more than 5,000 individuals who had acquired specific, cancer-associated driver mutations in their blood stem cells, called “clonal hematopoiesis of indeterminate potential” or CHIP, but who did not have blood cancer.
Using a genome-wide association study, the investigators then looked for genetic variations that were associated with different clonal growth rates. To their surprise, they discovered that a gene which had not previously been implicated in blood stem cell biology, was a major driver of clonal expansion when activated.
The researchers also found that a commonly inherited variant of the promoter, the DNA region which normally initiates transcription (and thus activation) of the gene, was associated with a slower clonal expansion rate and a markedly reduced prevalence of several driver mutations in CHIP, the second step in the development of blood cancer.
Experimental studies demonstrated that the variant suppresses gene activation.